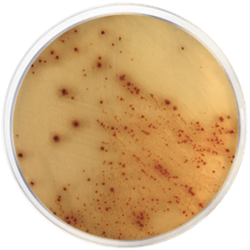

Base de agar cromogénico
Consultar tiempo de importación y entrega.
Vea nuestros productos en stock.
La base de agar cromogénico E. coli O157:H7 se utiliza para la detección de E.coli O157:H7. Este es un problema de salud generalizado que es responsable de la colitis hemorrágica que causa diarrea sangrante junto con dolor abdominal agudo.
E.coli O157:H7 produce varias citotoxinas, neurotoxinas y enterotoxinas, incluida la toxina Shiga. El tratamiento antibiótico incorrecto puede aumentar el riesgo de desarrollar síndrome hemolítico urémico, una complicación potencialmente mortal de esta forma de colitis. Tiene un reservorio bovino, por lo que la infección puede ocurrir después de la ingestión de carne de res poco cocida o leche sin pasteurizar. El organismo también se puede transmitir por vía fecal-oral.
Peptone Mixture proporciona nitrógeno, vitaminas, minerales y aminoácidos esenciales para el crecimiento y la mezcla cromogénica permite detectar fácilmente la presencia de
E.coli O157:H7 por la coloración de la colonia que crece de color rosa pálido. El telurito de potasio y la cefixima son altamente selectivos para E. coli O157:H7 e inhiben la mayoría de las bacterias contaminantes, incluidas otras cepas de E.coli y coliformes. El agar bacteriológico es el agente solidificante.
Aplicaciones Detección de Escherichia coli O157
Industria Clínico
Tamaño del paquete* 500 gramos
FÓRMULA
Agar bacteriológico 15
Mezcla cromogénica 2.8
Mezcla de peptona 20